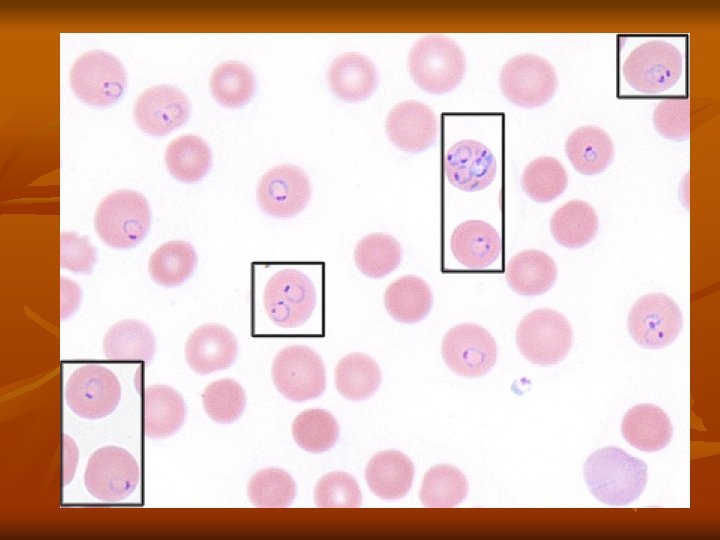
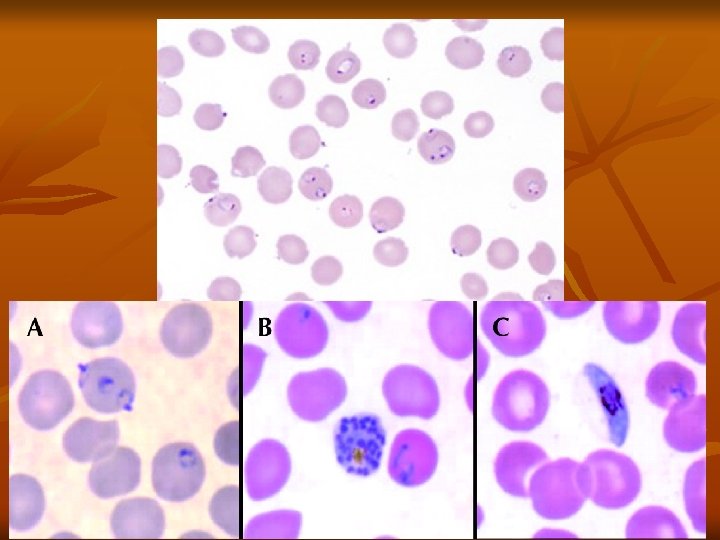

Class Sporozoa Protozoan parasites characterized by the production


Class Sporozoa -Protozoan parasites characterized by the production of spore-like oocysts containing sporozoites were known as sporozoa. -Intracellular, at least during part of their life cycle. -At some stage in their life cycle, they possess a structure called the apical complex, by means of which they attach to and penetrate host cells. -These protozoa are therefore grouped under the Phylum Apicomplexa. -The medically important parasites in this group are: Haemosporidia : Plasmodium Piroplasmidia: Coccidia: Babesia 1 -Toxoplasma 3 -Cryptosporidium 4 -Isospora 2 -Sarcocystis

Class: Haemosporidia Genus: Plasmodium Members of this genus are the cause of malaria. Species of plasmodia: 1 -Plasmodium vivax producing benign tertian malaria. It is the most widely distributed, being most common in Asia, North Africa, and Central and South America. It was found in Egypt. 2 - Plasmodium malariae producing quartan malaria. It is present in the tropics and subtropics. 3 -Plasmodium falciparum causing malignant subtertian malaria. It is the predominant species in Africa, Papua New Guinea, and Haiti, is rapidly spreading in South-east Asia and India. It is called malignant because it is misleading in diagnosis.

4 -Plasmodium ovale causing ovale tertian malaria. It is confined mainly to the tropics. Vector (definitive host): Human malaria is transmitted by female Anopheles mosquito. Intermediate host: Man. Mode of infection: 1 -Biological: By bite of female Anopheles mosquito. Infective stage is the sporozoite. 2 -Mechanical: Blood transfusion of an infected donor or among drug addicts. Infective stage is the schizont or merozoite. 3 -Congenital: This occurs through placental defects or during labor (connatal). Infective stage is the merozoite.

Life cycle of Plasmodium: The life cycle of the parasite is completed in two different hosts. 1 -Asexual cycle "Schizogony" occurs in man. a) Pre- erythrocytic and exo- erythrocytic cycle in liver cells. b) Erythrocytic cycle which takes place inside the RBCs 2 -Sexual cycle, "Gametogony" and "Sporogony" occur in the female Anopheles mosquito. Asexual cycle: (Schizogony) ) Pre-erythrocytic (exo-erythrocytic cycles): Life cycle of malaria started when infected female Anopheles bites a man, it injects the sporozoites into his blood (slender motile organisms).

It exist in the blood stream for about half an hour, then reach the liver cells to start a pre-erythrocytic cycle where they multiply producing schizonts, which lasts about 8 days. Rupture of liver schizonts release merozoites most of them invade quickly R. B. Cs. to begin the erythrocytic cycle. In P. vivax and P. ovale some merozoites re-invade liver cells and differentiate into nonsexual hypnozoites that remain dormant for weeks, or even years. The activated hypnozoites undergo exo-erythrocytic schizogony, forming a wave of merozoites that cause a relapse.


b)Erythrocytic cycle: Merozoites invade the red blood cells, where it grows and reproduces on the expense of the haemoglobin of the infected red blood cells. The developmental stages inside the R. B. Cs. are: - Ring stage. - Trophozoite. - Schizont. - Gametocyte. 1 -Ring stage: The parasite appears as a small rounded mass of cytoplasm with a single nucleus, and then a small vacuole rapidly develops inside the cytoplasm pushing the nucleus to one side, giving the parasite a ring shape.

2 -Trophozoite stage: The parasite shows a very active amoeboid movement with pseudopodia. Infected red cells are paler in color and in P. vivax they become larger in size. As a result of uptake of hemoglobin by the parasite, pigment granules appear in the cytoplasm of the parasite known as hemozoin (malarial pigment). 3 -Schizont stage: The parasite becomes rounded in shape, Nuclear division starts with binary fission resulting in the formation of a large number of daughter nuclei, followed by division of the cytoplasm that collects around each of the daughter nuclei leading to the formation of merozoites. Pigment granules tend to collect in the center of schizont.




Shcizogony take a period of 48 h in P. vivax, P. ovale, 36 -48 h in P. falciparum, and 72 h in P. malariae. Then the red blood cell ruptures releasing merozoites and hemozoin pigment, which is the cause of malarial paroxysm. Merozoites while circulating in the blood stream attack a new red blood cells and the cycle is repeated. 3 -Gametocyte stage: After repeated schizogony, some of the merozoites give rise to form gametocytes. Sexes are differentiated into male (microgametocytes) and female (macrogametocytes). These stages do not cause any febrile reaction; they are responsible only for the continuation of the cycle in the mosquito.



(2) Sexual cycle (Gametogony and Sporogony): 1 -Female Anopheles mosquito sucks up blood from a malarial patient. In the stomach of mosquito gametocytes transformed within few minutes into gametes (Gametogony). 2 -Male gametocyte (microgametocyte) develops by exflagellation through division of its nucleus into 4 -8 portions, each projects an actively moving filament and becomes a microgamete, which breaks off and the microgametes swim freely in the stomach contents. 3 -Female gametocyte (macrogametocyte) develops by nuclear reduction and becomes a macrogamete.

Fertilization takes place between the male and female gametes resulting "zygote". Zygote elongates and becomes motile and is called "ookinete". 4 -Ookinete bores its way through the epithelial cells lining the mucosa of mosquito's stomach, penetrates into the tissues and finally comes to rest just under the outer layer of the stomach wall. 5 -It is a spherical in shape and surrounded by a cyst wall thus is called "oocyst". 6 -Oocyst increases in size, nucleus divides into a large number of nuclei each becomes surrounded by the cytoplasm, giving rise to slender bodies with pointed ends termed "sporozoites".

7 -Occyst (sporocyst) ruptures and the sporozoites reach the salivary glands. Infection to man is by the saliva injected by the mosquito during biting to prevent blood coagulation. Pathogenesis All clinical manifestation in malaria are due to products of erythrocytic schizogony and the host’s reaction to them. Liver is enlarged and congested. Kupffer cells are increased and filled with parasites. Hemozoin pigments are also found in the parenchymal cells. Spleen is soft, moderately enlarged, and congested in acute infection. In chronic cases, spleen is hard with a thick capsule and slate grey or dark brown or even black in color due to dilated sinusoids, pigment accumulation, and fibrosis.



Anemia is caused by: a. Direct lysis of infected R. B. Cs by the parasite. b. Autoimmune lysis of infected and non-infected R. B. Cs. c. Increased R. B. Cs fragility. d. Splenic removal of both infected and non-infected R. B. Cs. e. Decrease R. B. Cs production due to bone marrow suppression. Clinical Features: a. Benign Malaria: The typical picture of malaria consists of periodic bouts of fever with rigor, followed by anemia and splenomegaly. Severe headache, nausea, and vomiting are common. The febrile paroxysm comprises of 3 successive stages cold stage, hot stage, and sweating stage.

1. Cold stage, that lasts for 15– 60 minutes, there is intense cold and uncontrollable shivering. 2. Hot stage, lasting for 2– 6 hours, when the patient feels intensely hot. Temperature mounts to 41°C or higher. 3. Sweating stage, there is profuse sweating. Temperature drops rapidly and the patient usually falls into deep sleep, to wake up refreshed. Febrile paroxysm synchronizes with the erythrocytic schizogony. The periodicity is approximately 48 hours in tertian malaria (in P. vivax, P. falciparum, and P. ovale) and 72 hours in quartan malaria (in P. malariae). Hypoglycemia or hyperglycemia may occur in malarial attacks.

Sometimes, there may be hyperkalemia due to red cell lysis and fall in blood p. H. Anemia, splenomegaly, and hepatomegaly. Although P. malariae malaria is less severe, but it may lead to renal complications. b. Malignant tertian Malaria: The most serious and fatal type of malaria is malignant subtertian malaria caused by P. falciparum. If not treated promptly and adequately, dangerous complications develop. The term pernicious malaria has been applied to a complex of life-threatening complications. These may present in various forms, the most important of which are the cerebral, algid and septicemic varieties

In falciparum malaria the phenomenon of cytoadherence which leads to diminished tissue perfusion causing severe complications. Cytoadherence is a unique phenomenon occurred in P. falciparum infection, due to the ability of the mature parasitized RBC (p. RBC) to undergo a range of adhesive interactions (cytoadhesion), such as the binding of p. RBC with endothelial cells (sequestration) and the interaction of p. RBC with non-infected RBC (rosetting) and with other p. RBC (autoagglutination). Small vessels may thus become plugged by masses of parasitized red blood cells. Ischemia consequent to plugging of the vessels produces symptoms that vary with the organ involved and the degree of tissue anoxia.

1. Cerebral Malaria: It is the most common cause of death in malignant malaria. Even with treatment, death occurs in 15% of children and 20% of adults who develop cerebral malaria. Severe headache, hyperpyrexia, coma or confusion, and paralysis. Late stage schizonts of P. falciparum secrete a protein on the surface of RBCs to form knob-like deformities. This knob produces specific adhesive proteins, which promote aggregation of infected RBCs to other non-infected RBCs and capillary endothelial cells. These sequestrated RBCs cause capillary plugging of cerebral microvasculature, which results in anoxia, ischemia, and hemorrhage in brain.

2. Blackwater fever: A syndrome called blackwater fever (malarial hemogloblinuria) is sometimes seen in falciparum malaria, particularly in patients, who have experienced repeated infections and inadequate treatment with quinine. Clinical manifestation include bilious vomiting and prostration, with passage of dark red or blackish urine (black water). It is due to massive intravascular hemolysis caused by antierythrocyte antibodies, leading to massive absorption of hemoglobin by the renal tubules (hemoglobinuric nephrosis) producing black water fever.

Complications of black water fever include renal failure, acute liver failure, and circulatory collapse. 3. Algid Malaria: This syndrome is characterized by peripheral circulatory failure, rapid thready pulse with low blood pressure, and cold clammy skin. There may be severe abdominal pain, vomiting, diarrhea, and profound shock. 4. Septicemic malaria: It is characterized by high continuous fever with dissemination of the parasite to various organs, leading to multiorgan failure. Death occurs in 80% of the cases.

Immunity: Immunity in malaria may be classified as innate immunity and acquired immunity. Innate Immunity: Many factors affect plasmodium infection: Duffy negative RBCs: It has been found that persons, who lack the Duffy blood group (Fya and Fyb alleles) antigen, are refractory to infection by P. vivax. These genetically determined blood group antigen appears to be the specific receptor for P. vivax. Nature of hemoglobin: Hemoglobin E provides natural protection against P. vivax.

P. falciparum does not multiply properly in sickled red cells containing Hb. S. Sickle cell anemia trait is common in Africa. Hb. F present in neonates protects them against all Plasmodium species. G 6 PD deficiency: Innate immunity to malaria has also been related to G 6 PD deficiency. HLA-B 53: HLA-B 53 is associated with protection from malaria. Pregnancy: Falciparum malaria is more severe in pregnancy, particularly in primigravida and may be enhanced by iron supplementation. Splenectomy: The spleen appears to play an important role in immunity against malaria. Splenectomy enhances susceptibility to malaria.

Acquired Immunity: Infection with malaria parasite induces specific immunity involving both humoral and cellular immunity, which can bring about clinical cure, but cannot eliminate parasites from the body. It can prevent superinfection, but is not powerful enough to defend against reinfection. This type of resistance in an infected host, which is associated with continued asymptomatic parasite infection is called premunition. This type of immunity disappears once the infection is eliminated.

Young children are highly susceptible to malaria. As they grow up, they acquire immunity by subclinical or clinical infections, so that incidence of malaria is low in older children and adults. Premunition: It is a protective immunity to super infection. It is effective only as long as a low grade parasitemia is present, which stimulate immune bodies against the parasite. If the parasite is completely eradicated, the immunity disappears and the patient is liable to re-infection.

Recrudescence and Relapse: a. Recrudescence: It occur in P. falciparum and P. malariae infections after the primary attack. , sometimes there is a period of latency, during which there is no clinical illness. Some parasites persist in some erythrocytes, erythrocytic schizogony continues at low levels, leading to a new malarial attack developed, which is called recrudescence. Recrudescence may be due to waning immunity of the host or possibly due to antigenic variation. In P. falciparum infections, recrudescence are seen for 1– 2 years, while in P. malariae infection, they may last for long periods, even up to 50 years.

b. Relapse: It is seen in P. vivax and P. ovale infections. In both these species, 2 kinds of sporozoites are seen, some of which multiply inside hepatocytes promptly to form schizonts and others which remain dormant. These latter forms are called hypnozoites (from hypnos: sleep). Hypnozoites remain inside the hepatocytes for long periods. Reactivation of hypnozoites leads to initiation of a new erythrocytic cycles and new attacks of malarial fever. Such new attacks of malaria, caused by dormant exoerythrocytic forms, reactivated usually from 24 weeks to 5 years after the primary attack are called relapses.

Diagnosis: Demonstration of Parasite by Microscopy: - Diagnosis of malaria can be made by demonstration of malarial parasite in the blood. - Two types of smears are prepared from the peripheral blood. One is called thin smear and the other is called thick smear. Immunological techniques: - Antibody-based techniques: using (IFAT) and (ELISA) - Antigenbased techniques: using Rapid Diagnostic Test (RDT). Molecular techniques: Polymerase Chain Reaction (PCR): Using PCR amplification.

Treatment: A- General and supportive measures: 1 - Bed rest, cold fomentations , antipyretics and sedative in malarial attacks. 2 - Fluid replacement and blood transfusion may be necessary. B- Chemotherapy: 1 - Clinical cure: Treatment of acute attack by destruction of asexual erythrocytic forms. a. For all plasmodia except resistant P. falciparum : Chloroquine phosphate : Oral dose of 1 gm initially , 0. 5 gm after 6 hours and 0. 5 gm daily for 2 days.

b. For persistent P. falciparum : Quinine sulphate + combination of pyrimethamine / sulphadoxine. Quinine sulphate: Oral dose of 650 mg 3 times daily for a week. Pyrimethamine (500 mg) / sulphadoxine (25 mg): Oral dose of 3 tablets at the last day of quinine sulphate. 2 - Radical cure: Prevention of relapses in P. vivax and oval by destruction of the late pre- erythrocytic forms: Primaquine phospate : Oral dose of 23. 6 mg (15 mg base) daily for 2 weeks.

3 - Prophylaxis: Prevention of primary attack and clinical symptoms by destruction of pre-erythrocytic forms , in patients visiting an endemic areas. - For chloroquine sensitive: Chloroquine phosphate: Oral dose of 0. 5 gm weekly , a week before entering and 6 weeks after leaving the endemic area. -For chloroquine resistant : Mefloquine: Oral dose of 250 mg weekly, a week before entering and 4 weeks after leaving the endemic area. Doxycycline: Oral dose of 100 mg daily , a day before entering and 4 weeks after leaving the endemic area.

Combination of pyrimethamine (500 mg) and sulphadoxine (25 mg): Oral dose of one tablet weekly , a week before and 4 weeks after leaving the endemic area. Prevention and control: 1 - Personal protection from mosquitoes bites e. g. by using of skin repellents and bed nets. 2 - Mosquitoes control. 3 - Treatment of infected cases to reduce the source of infection. 4 - Health education about the hazards and methods of transmission of the parasite.
- Slides: 40